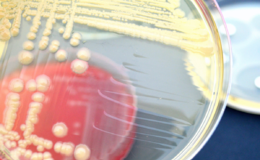

Techmate Ltd

Techmate Ltd
10 Bridgeturn Avenue
Old Wolverton
Milton Keynes
Bucks
MK12 5QL
10 Bridgeturn Avenue
Old Wolverton
Milton Keynes
Bucks
MK12 5QL
Techmate is a family run labware supply business, working with many pharmaceutical companies, medical and life science research agencies, government and local authority establishments.
Although we are the original labware supplier of Nalgene labware, we are also able to supply products from most labware manufacturers, enabling customers to have a “one stop shop”.
Unlocking the Microbial World: Exploring Essential Microbiology Products
Microbiology is the fascinating branch of science that delves into the unseen world of microorganisms. From life-saving antibiotics to brewing beer, microbiology plays a crucial role in diverse field…
Get Techmate Ltd news direct to your inbox
Informative Newsletters & Tailored Alerts
Free Digital Journals
Unrestricted Access To Content & Downloads




